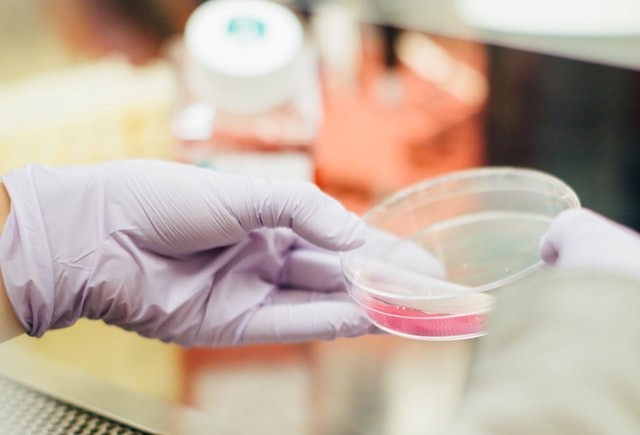

L’allergia agli alimenti è una condizione che si verifica quando il sistema immunitario reagisce a un alimento normalmente innocuo. Frutta secca, latticini e uova sono i cibi che seguono a ruota il grano nella lista degli alimenti problematici, quelli che con sintomi più o meno invasivi, rendono la quotidianità decisamente più complicata.
A seconda del livello di gravità dell’allergia, le reazioni possono essere più o meno invalidanti e nei casi peggiori, come per lo shock anafilattico, le conseguenze possono essere anche fatali. Approfondiamo l’argomento sviscerandone principali allergeni, sintomi e trattamenti.
Allergia alimentare, definizione
Volendone dare una definizione più precisa, l’allergia alimentare è una reazione del sistema immunitario a un determinato cibo, percepito dall’organismo come nocivo. Basta assumerne anche solo una piccola quantità per assistere alla stessa, che può manifestarsi sotto forma di diversi sintomi.
A differenza di quanto si possa pensare, il problema principale però non è quando l’allergia alimentare è conclamata. Quando il disturbo è grave, infatti, risulta più semplice fare attenzione a quello che si mangia o con cui si entra in contatto. Purtroppo per i casi meno eclatanti si arriva a riconoscere l’allergia tardi, confondendo i sintomi con altri tipi di patologie, normalmente a carico della cute o del sistema gastroenterico.
Intolleranza alimentare
Un cenno merita un disturbo simile, che causa spesso confusione. Seppur apparentemente simili, l’allergia e l’intolleranza alimentare sono diverse. Quest’ultima, in particolare, si verifica quando il corpo ha una reazione chimica al consumo di un particolare alimento o bevanda. L’intolleranza alimentare non coinvolge il sistema immunitario e non provoca gravi reazioni allergiche.

Allergie alimentari, lista
I tipi di allergie alimentari sono diversi. Cambiano, ovviamente, in virtù del cibo o, meglio, dell’allergene che le scatena. Quelli più comuni, ovvero responsabili della quasi totalità delle allergie alimentari individuati e disciplinati dal Regolamento Europeo 1169/2011 sono i seguenti 14.
I principali allergeni alimentari che provocano i sintomi di una reazione allergica sono:
- Uova
- Pesce
- Latte
- Arachidi
- Crostacei
- Soia
- Frutta a guscio
- Cereali e derivati
- Sedano
- Sesamo
- Senape
- Anidride solforosa e solfiti
- Lupini
- Molluschi
È doveroso ricordare il fatto che si possa sviluppare un’allergia a qualsiasi tipo di cibo (non solo a quelli contenuti nella lista).
Cause delle allergie alimentari
La causa principale delle allergie alimentari consiste nel fatto che il sistema immunitario riconosce come nociva una specifica proteina di un alimento. Ciò causa una risposta ben precisa da parte dello stesso, che consiste nella produzione di anticorpi IgE (immunoglobine) volti ad attaccare tale proteina.
Ogni volta che la persona mangerà lo stesso alimento, il sistema immunitario reagirà immediatamente rilasciando istamina e altre sostanze chimiche nel flusso sanguigno. Le stesse che causano i sintomi delle allergie alimentari. L’istamina, infatti, causa l’espansione dei vasi sanguigni e l’infiammazione o il gonfiore della pelle. È responsabile anche del prurito, perché colpisce anche i nervi.
Soggetti a rischio
Chiunque può sperimentare un’allergia alimentare, ma alcuni fattori di rischio rendono più probabile lo sviluppo in determinati soggetti. Si tratta, in particolare, di chi ha alle spalle una storia familiare di allergie, di chi soffre di altre condizioni allergiche, dei batteri intestinali.

Allergia alimentare, sintomi
I sintomi di una reazione allergica alimentare solitamente coinvolgono l’apparato digerente, ma non solo. Possono interessare anche altre parti del corpo o causare una sensazione di malessere generale.
Le allergie alimentari – così come quelle di altra natura, come ad esempio l’allergia al polline e l’allergia al nickel – provocano anche sintomi sulla pelle. Quelli più comuni includono:
- mal di stomaco e dolore addominale
- orticaria o eruzioni cutanee
- gonfiore delle labbra o delle palpebre
- prurito alla bocca e alla gola
- gonfiore della lingua
- voce rauca
- difficoltà a deglutire
- tosse o mancanza di respiro
- vomito
- diarrea
- vertigini
- svenimento
- mal di testa
- naso che cola
- sensazione generale di malessere
La gravità dei sintomi è associata spesso alla quantità dell’allergene che si è ingerito. Anche se, è bene specificarlo, spesso determinare se tali manifestazioni siano dovute ad una intolleranza o ad una allergia può risultare difficile. A volte si può fare perfino confusione tra i sintomi di un raffreddore e quelli di un’allergia.
Reazione allergica alimentare, dopo quanto si manifesta
I sintomi delle allergie alimentari possono richiedere del tempo prima di emergere. Il loro esordio si può verificare anche diverse ore dopo l’avvenuta ingestione. Se vi chiedete quanto dura una reazione allergica alimentare, le sue manifestazioni possono persistere per diverse ore o giorni. Quello che è certo, è che una volta che si è presa coscienza del problema, tramite citotest sanguigno e patch test, è importante rimodulare la propria vita affinché allergie e intolleranze non la rendano difficile.
Diagnosi
Per diagnosticare un’allergia, in sede di visita di controllo il medico chiederà al paziente notizie riguardanti le reazioni manifestate a seguito di ingestione di un particolare alimento per accertarsi dei sintomi, di quando e come compaiono, della loro durata. Appurata l’eventuale storia familiare di allergie della persona, potrebbe chiedere l’esecuzione di alcuni test. Come ad esempio:
- Prick test: consiste nel posizionare sul braccio del soggetto cibi diluiti perforando leggermente la pelle in corrispondenza degli stessi. Nel momento in cui dovesse manifestarsi una qualsiasi reazione, ciò sarebbe la prova di un’allergia.
- Analisi del sangue: queste servono a ricercare la presenza di anticorpi specifici per determinate proteine alimentari che possono indicare un’allergia.
- Diario alimentare: utile è infine annotare in un diario cosa si mangia e quali sono le reazioni a seguito dell’ingerimento, se si verificano.
Cura delle allergie alimentari
Reazione allergica alimentare, cosa fare? La prima e migliore cura in caso di allergia alimentare consiste nell’evitare di mangiare l’alimento responsabile della stessa. Inoltre, è bene avere con sé sempre a disposizione alcuni farmaci di emergenza. Il medico può prescrivere medicinali che riducono i sintomi della reazione allergica. Come ad esempio:
- Epinefrina, farmaco di emergenza salvavita che inizia immediatamente a invertire i sintomi dell’anafilassi.
- Antistaminici, farmaci che riducono il prurito o la congestione.
- Corticosteroidi, utili per ridurre il gonfiore in caso di grave reazione allergica.
Se vi chiedete quale antistaminico per allergie alimentari prendere, sarà il medico a prescrivere quello più adatto alle vostre condizioni. Si consiglia inoltre di indossare un’identificazione di allerta medica che indichi le proprie allergie alimentari. Purtroppo non esiste, ad oggi, un modo per prevenirle. L’unica cosa che si può fare per evitarle è leggere le etichette e chiedere cosa c’è nel cibo prima di mangiarlo.

Allergia agli alimenti, consigli utili
Imparare a riconoscere i sintomi. Non solo i sintomi in sé ma anche la loro entità. Se uno di questi tende a peggiorare o si somma a nuovi disturbi, dobbiamo essere pronti a saper affrontare la situazione.
Imparare a leggere correttamente le etichette dei cibi confezionati. Nelle liste ingredienti dei cibi, spesso ci si perde, soprattutto quando i nomi sono sostituiti da codici. Fortunatamente in Italia molti marchi noti specificano in grassetto gli allergeni. Tuttavia, in caso di intolleranze gravi, attenzione anche alla dicitura “può contenere tracce di”, perché anche le micro tracce di una sostanza allergizzante possono fare danni.
Seguire una terapia per la gestione della sintomatologia. Il modo migliore per tenere sotto controllo allergie alimentari e intolleranze è quello di farsi seguire da uno specialista, che potrà prescrivere la giusta terapia e fornire suggerimenti per desensibilizzare l’organismo, dove possibile, o comunque gestire nel modo migliore possibile il problema.
Imparare a gestire le eventuali emergenze. Quando l’allergia è grave, bisogna essere correttamente preparati anche ad eventuali emergenze. Riconoscere i sintomi dell’anafilassi e saper dare indicazioni prontamente a chi ci sta accanto o al personale medico, può salvare la vita.
Tenere sempre con sé alimenti privi di allergeni. Attenzione anche a non sottovalutare gli spostamenti. Quando siamo fuori casa cerchiamo di tenere sempre con noi una piccola scorta di alimenti senza allergeni, su cui fare affidamento se per qualche imprevisto non possiamo consumare un pasto completo e non c’è la possibilità di acquistare prodotti allergens free. In borsa, in tasca o nel cassetto della scrivania dell’ufficio, mai fare mancare quello di cui si ha bisogno.












